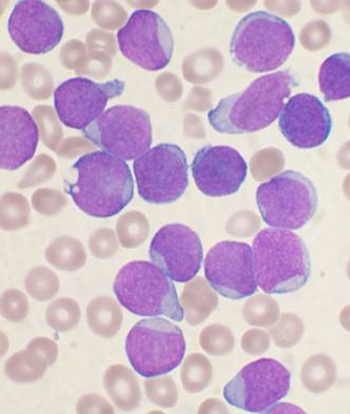

Adding radiotherapy to adjuvant chemotherapy in the ARTIST trial yielded similar results to chemo alone in patients with D2 lymph node-resected gastric cancer.

Your AI-Trained Oncology Knowledge Connection!


Adding radiotherapy to adjuvant chemotherapy in the ARTIST trial yielded similar results to chemo alone in patients with D2 lymph node-resected gastric cancer.

Adding linifanib to a carboplatin/paclitaxel regimen improved progression-free survival over placebo in advanced non-squamous NSCLC patients.

Clonal hematopoiesis with somatic mutations is strongly associated with the risk of developing blood cancers, according to a new study.
According to a report, two courses of the newly approved agent blinatumomab, for relapsed or refractory B-cell precursor ALL, will cost a staggering $178,000.

The US Food and Drug Administration approved lanreotide for the treatment of patients with gastroenteropancreatic neuroendocrine tumors.

An analysis showed that etoposide-cisplatin or carboplatin-paclitaxel with RT yielded similar survival in patients with stage III non-small-cell lung cancer.

A large trial showed that treatment-emergent vasomotor and/or joint symptoms do not correlate with any improvement in recurrence-free survival in postmenopausal breast cancer patients treated with aromatase inhibitors.

The FDA has approved the combination of ramucirumab and docetaxel for the treatment of patients with metastatic non-small-cell lung cancer.

An extremely large database study across more than one million people found no increased risk of bladder cancer with the diabetes drug pioglitazone.

A large phase I study showed that the PD-L1 antibody known as MPDL3280A has promising activity in patients with urothelial bladder cancer.

In a new trial, amrubicin showed a slight improvement for patients with refractory small-cell lung cancer in the second-line setting.

Pancreatic cancer patients with long-standing diabetes have poorer survival than those without diabetes, according to an analysis of a pair of studies.

Amgen has halted clinical trials of rilotumumab in gastric cancer after a planned safety review showed an increase in the risk of death with the study drug.

More than 11% of all eligible women had not been screened for cervical cancer in the past 5 years, according to a study by researchers at the CDC.

New research suggests that characterizing low-grade gliomas according to molecular markers may be a more useful approach in order to guide treatment decisions.

A core set of symptoms are common across brain tumor patients and underscore the complexity of brain tumors and their management.

Depressive symptoms and impaired executive functioning, both common in patients with glioblastoma, are independently associated with shorter overall survival.

Adding the HDAC inhibitor valproic acid to decitabine did not improve outcomes in patients with myelodysplastic syndromes or acute myeloid leukemia.

The immunotherapeutic rindopepimut with bevacizumab yielded a significant survival improvement in relapsed glioblastoma patients with a EGFRvIII mutation.

A phase I trial of an oncolytic polio/rhinovirus vaccine was safe and showed promising efficacy in patients with recurrent glioblastoma.

Treating newly diagnosed glioblastoma with “tumor treating fields” is a safe and effective therapeutic option, according to a new trial.

A small trial yielded “dramatic” results with high progression-free and overall survival using SBRT along with erlotinib for patients with stage IV lung cancer.

A combination of bevacizumab and lomustine showed promise in a randomized phase II trial of patients with recurrent glioblastoma, according to study results.

The addition of procarbazine, CCNU, and vincristine to RT in patients with low-grade glioma prolongs progression-free and overall survival vs RT alone.

Hispanic childhood cancer survivors are less likely to receive follow-up care later in life than white survivors, according to a new study.

The Centers for Medicare & Medicaid Services announced plans to cover low-dose CT screening for lung cancer, based mainly on the National Lung Screening Trial.

The FDA approved ramucirumab (Cyramza) in combination with paclitaxel for treating patients with advanced gastric or gastroesophageal junction adenocarcinoma.

About 9% of pancreatic cancer cases appear to be familial, and the risk of cancer in relatives of these patients does not appear limited to the pancreas.

A study of next-generation genetic sequencing found the techniques to be feasible and useful in NSCLC patients, producing actionable results in a large proportion of patients.

Vaccines including that for HPV, which helps prevent cervical cancer, show no association at all with multiple sclerosis or other CNS demyelinating syndromes.